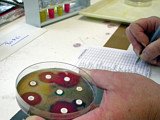

Suche nach:
Themenliste Technik
829 Bilder. Nicht gewünschte Suchbegriffe durch Anklicken löschen.
829 Bilder. Nicht gewünschte Suchbegriffe durch Anklicken löschen.